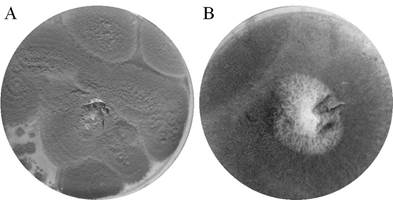

1. Introduction
Polyvinyl chloride (PVC), is a thermoplastic mainly used in pipes, household implements, furniture, upholstery, disposable products like food and pharmaceutical products packaging and medical devices (Giacomucci, Raddadi, Soccio, Lotti, & Fava, 2020). Due to its great demand because of its properties, high amounts of waste of this material are generated. It has been estimated that since the beginning of the widespread use of plastic, 6.3 billion tons of these materials have been produced and that roughly 79% of the waste is disposed of in landfills. This could lead to 2.41 million tons of plastic waste ending up in the oceans annually (Lebreton et al., 2017). Plastic is made to last, so plastic wastes are persistent materials that undergo physical changes by environmental conditions, resulting in very tiny fragments called microplastics, which are currently found both in very populated places as well as remote and unpopulated ones (Bergmann et al., 2019). In Colombia, plastic uptake in 2018 increased by 8.3% compared to 2017 with 220 thousand tons of PVC resin consumed (Acoplásticos, 2019). This scenario shows the importance of establishing plastic degradation techniques, among other policies, that allow us to reduce plastic wastes.
Incineration is still a conventional way of disposing wastes in some countryside regions, but this PVC-containing waste produces hazardous products when it is heated because it releases free radical molecules, CO, free ions and hydrogen chloride (Vivi, Martins-Franchetti, & Attili-Angelis, 2019). Although PVC is recalcitrant to biodegradation, there are research reports that showed bacteria and fungi that can degrade this material (Raddadi & Fava, 2019). Fungi seems a good option, because they have the capacity to degrade organic chemicals with a very low specificity, they are ubiquitous, they can spread fast through mycelial networks and grow at low pH values (Harms, Schlosser, & Wick, 2011). In addition, Fungi are able to produce hydrophobins that allows them to attach to hydrophobic substrates, and colonize them, which would be the first step to their degradation (Sánchez, 2020).
Few published studies on the degradation of PVC from fungi are found in the scientific literature. Kirbas, Güner and Keskin (1999), studied the degradation of PVC with the fungal species Pleurotus sp., Poliporus versicolor and Phanerochaete chrysosporium, where the former showed the best results with 19.32% degradation and 82.15% decrease in C-H bonds, while the latter showed percentages lower than 13.17%. On the other hand, Ali et al. (2014), tested the degradation of PVC films with the fungal species Phanerochaete chrysosporium, Lentinus tigrinus, Aspergillus niger and Aspergillus sydowii, finding changes in the color and deterioration on the analyzed films. In addition, they found a biomass increase in each one of the fungi tested which evidenced the use of PVC as carbon source by fungi. Finally, Sumathi, Viswanath, Lakshmi and SaiGopal (2016), isolated the fungus Cochliobolus sp., from plastic dumped soils and studied the degradation of low molecular weight PVC by laccase enzyme from the fungus. They founded that PVC treated with the fungus was significantly degraded compared with the controls.
The aim of the present work was to study the degradation of PVC films, without plasticizer, by fungi isolated from an environmental sample of soil contaminated with PVC resin. Considering that this soil has been exposed to PVC resin since some decades ago, this could favor the growth of microorganisms capable of degrading the resin. To achieve this objective, fungi were isolated from soil, they were subjected to preliminary tests to look for those that showed some PVC degradation capacity and finally, with best results isolates, we built growth curves.
2. Materials and methods
2.1 Isolation and morphological characterization of fungi
Samples of soil contaminated with PVC resin, were taken from the ground under a PVC silo in a company that manufactures and markets products of this material in Bogotá, Colombia. The resin on the ground was evident in the sampled area. The pits for these samples were 50 cm deep, distributed in five different spots of the ground of approximately 6 m2 in area, in a zigzag pattern, locating a spot every 3 m. These samples were then mixed, sieved, and homogenized. Ten gr of this soil were mixed with 100 mL of enrichment medium containing 0.025 g of K2PO4, 0.0625 g of MgSO4(7H2O, 0.0125 g of CaCl2(2H2O, 0.0625 g of NH4NO3, 0.0125 g of yeast extract, 1.25 g of glucose and 1 g of PVC resin in 1 L of distilled water. This mixture remained five weeks at 25ºC and stirred at 150 rpm (Ali et al., 2014).
Serial dilutions of 1x10-1, 1x10-2 and 1x10-3 were made; 100 µL were taken from each dilution and seeded in triplicate in Czapek, malt extract and PDA culture media. From these media, the fungal morphospecies were picked to isolate them. Subsequently, the macroscopic morphological characterization was performed, according to the appearance of the colonies, and the microscopic characterization was carried out by staining them with lactophenol blue. Observations were performed under a Primo StarTM Zeiss microscope (Carl Zeiss Microscopy, Jena, Germany) and the Domsch and Gams keys (Domsch K., Gams W & Anderson, T. 1980) were compared.
2.2 Preparation of PVC films
PVC films (6.2 x 2.5 cm), were prepared from 0.2 g of PVC resin and 10 ml of tetrahydrofuran. The films obtained were washed with distilled water and 96% ethanol for 15 min (Ali et al., 2014). We also investigated if a heat treatment on the PVC films made fungal biodegradation easier, for which, one run was carried out with films heated at 150°C for 1 h (Films C) (De Campos & Martins Franchetti, 2005), while other run was performed with films without heat treatment (Films SC).
2.3 Screening of PVC degrading fungi
From the isolates obtained, eight were chosen for preliminary tests. Clean films with and without heat treatment were incubated with the fungal isolate and 20 ml of minimum salt medium (MSM) with the following composition: 1.0 g of K2HPO4, 0.20 g of KH2PO4, 1.0 g of NaCl, 0.002 g of CaCl2(2H2O, 0.005 g of boric acid, 1.0 g of NH4SO4, 0.5 g of MgSO4(7H2O, 0.001 g CuSO4, 0.01 g of ZnSO4(7H2O, 0.001 g of MnSO4 and 0.01 g of FeSO4 per liter of distilled water (Ali et al., 2014). Tubes with films, MSM and fungi were incubated at 30 °C and stirred at 150 rpm for 6 weeks. Experiments were performed in triplicate. We carried out two types of controls, one for fungi and another for film. The fungi controls were performed for each isolation tested and consisted of fungus with MMS without film, and the film control consisted of PVC film with MMS without fungus. After incubation, we proceeded to review the macroscopic modifications on the films, observing for changes in color, occurrence of holes and development of microorganisms on the surface (Lucas et al., 2008). In addition, the fungus mass was collected, filtered, dried at 60 °C for 72 hours and weighed to compare its growth vs. controls (Hamzah, Manikan, & Abd Aziz, 2017). Also, the spectra of the films were obtained by FTIR at the end of the test and compared with the spectra at the beginning. Finally, the gravimetric weight loss of the PVC films was obtained as follows (Giacomucci, Raddadi, Soccio, Lotti, & Fava, 2020):
Weight loss (%) = (initial PVC film weight - final PVC film weight)/ initial PVC film weight*100
2.4 Molecular identification of the two fungal isolates with better results
The chosen isolates were sent to the Corpogen corporation where the DNA was extracted and purified using the PowerSoil® DNA Isolation Kit (MO BIO Laboratories Inc.). The Internal Transcribed Spacer (ITS) regions were amplified using the universal primers ITS5 (5′-GGAAGTAAAAGTCGTAACAAGG-3′) and ITS4 (5′-TCCTCCGCTTATTGATATGC-3′) regions (White, Burns, Lee, & Taylor, 1990). The PCR conditions were: 5 min. at 95°C, followed by 35 cycles of 30 s at 95°C, 30 s at 55°C and 45 s at 72°C, followed by 5 min. at 72°C. Electrophoresis was carried out to confirm the expected PCR products. Fragments obtained were purified and sequenced by the Sanger method. With the assembled sequences of about 600 bp, a preliminary species assignment was carried out based on sequence similarity values of 97 to 100% against GenBank. With the sequences with the highest % similarity and those obtained, an alignment was made using the Muscle algorithm, the dendrogram was constructed using Mega X software (Kumar, Stecher, Li, Knyaz, & Tamura, 2018).
The GenBank accession numbers for the nucleotide sequences obtained in this study, are MT509528 and MT509529.
2.5 Growth curves
With the two isolates with better results in the screening test, growth curves were built from monosporic cultures of each isolate, following the same procedure performed for screening test, using PVC films without heating treatment. Data were collected every 7 days for 15 weeks, recording the mass gained by the fungi and the FTIR spectra of each film exposed to the fungal species. Like the screening test, controls were performed by running the test with fungus and MMS without films, and with films and MMS without fungus.
2.6 Statistical analysis of data
For the screening tests, an analysis of variance (ANOVA) was initially performed, no significant inequalities were found in the heat treatment tested, so a box plot was made as an alternative to observe the differences between one treatment and another. Non-heated films were chosen to evaluate PVC films degradation in the screening test. In order to assess if there were significant differences in fungal masses and gravimetric weight losses among the fungi tested, we performed one-way ANOVA, followed by a post-hoc Tukey test. For the growth curves, the t-test was used for two samples, assuming equal variances, to show differences between pairs of weeks during the study. Statistically significant results were represented by p-values <0.05. Statistical analyses were performed using the JMP trial statistical software package, version 15.2.1 (SAS Institute Inc, Cary, NC).
3. Results and discussion
3.1 Isolation and morphological characterization of fungi
Thirty morphotypes that presented macroscopic differences were isolated. From these, the most morphologically different were chosen and characterized macro and microscopically, comparing their characteristics with the keys of Domsch and Gams. Eight genera were identified: Gliocladium, Streptomyces, Piptocephalis, Tetrachaetum, Sympodiella, Synnematium, Penicillium, and Mucor. Table 1 shows the macro and microscopic characteristics found for each isolate (Domsch et al., 1980; Barnett & Hunter, 1972; Pacasa-quisbert, Loza-murguia, Bonifacio-flores, Vino-nina, & Serrano-canaviri, 2017).
Table 1 Morphological description of the isolated fungal strains.
| Code | Genus | Macroscopic description | Microscopic description | |
| Obverse | Reverse | |||
| D3 | Glicocladium | Fast growing circular colony, dark brown to black and cottony in texture. | Black | Hyaline conidiophores, with branches of penicilate, forming a compact brush. |
| L | Streptomyces | Cottony irregular colony, light yellow and white. | Yellow and white | Tiny spores produced in chains by segmentation hyphae. |
| W | Piptoceph | White colony at the beginning, then yellowish cottony and orange at the end. | Pale pink | Little branched conidiophores |
| M | Tetrachaetum | Pink circular colony, with white filamentous edges. | Yellowish cream, white | Simple thin conidiophores sparsely branched. Apical conidia, hyaline, with long branches diverging from a common point. |
| E10 | Sympodiella | The colony is spread out in a cottony, white, and red color. | Light yellow | Long chains are observed. Simple, dark, hyaline solitary conidiophores in unbranched chains joined laterally, cylindrical with blunt ends. |
| F | Synnematium | Circular colony, white and pink on the edges, woolly texture. | Deep yellow with streaks | Hyphae thin tapered to a pointed tip, hyaline conidia. |
| AB | Penicillium | Green circular colony with white edge, dusty texture. | Light yellowish brown | Conidiophores arising from individually branched mycelium near the apex, hyaline conidia, most globose or ovoid. |
| Q | Mucor | Brown circular colony, white at the center, cottony texture. | Light brown | Conidiophores in ball shaped clusters. |
3.2 Screening of PVC degrading fungi
To compare the fungal biodegradation in PVC films previously treated with and without heat, a one-way ANOVA was performed and showed that there was no statistical difference between treatments (P=0.944; F=0.0051; df=47). In addition, a box-and-whisker plot was built with the data obtained (Figure 1). It shows that there is no significant difference between the mass gained by the fungi from heat-treated PVC film versus fungi from non-heat-treated PVC film, since the medians obtained for both treatments are very similar, as evidenced by the lines inside the boxes. The atypical data is also shown.
For screening test, we evaluated fungal biodegradation by calculating fungal masses (Figure 2) and gravimetric weight loss percentage by PVC films (Figure 3). We obtained results of ANOVA analysis that showed a statistically significant difference among fungal masses (p<0.0001; F=51.77; df=15) and weight loss percentage (p<0.0001; F=353.54; df=8). The best results were exhibited for AB and Q isolates. In fact, Figure 2 shows that both, AB and Q isolates, had a statistically significant increase of biomass compared with their controls (p<0.05). This trend is not evidenced for the other isolates tested.

Figure 2 Fungal mass reached in the screening test for the eight isolates analyzed. C letter in fungal isolates is used to differentiate controls run for each isolate. Standard deviation of triplicate measurements is shown as error bars. Letters a, b, c, d, e show results of post-hoc analyses and different letters indicate a significant statistical difference in fungal mass value (p<0.05)

Figure 3 Gravimetric weight loss percentage by PVC films in the screening test for the eight isolates analyzed.
In figure 3, PVC stands for the film used in the control test. Standard deviation of triplicate measurements is shown as error bars. Letters a to e, show results of post-hoc analyses and different letters indicate a significant statistical difference in weight loss value (p<0.05). Figure 3 shows that PVC films from isolates AB and Q also have a statistically significant percentage weight loss compared with the control, which was a PVC film incubated under the same conditions as samples but without fungus (p<0.05). Indeed, we observed that films from these isolates showed much more cracks and opacity compared with the films from other fungi.
FTIR spectra of all the films exposed to fungal isolates were obtained. However, we only include spectra from Q and AB (Figure 4), as they were the best results. The spectrum of the PVC film from a blank test, represented in solid line, shows two strong bands between 3000 and 2900 cm-1 corresponding to C-H stretching of CHCl and CH2. A deformation band of CH2 is found near 1400 cm-1, and two more C-H deformation bands of CHCl are seen between 1350 and 1200 cm-1. Close to 1100 cm-1 there is a C-C stretching band, near 1000 cm-1 is shown a rocking band of CH2 and finally, between 700 and 600 cm-1 there are three C-Cl stretching bands (Park, Park, Kim, Canlier, & Hwang, 2018). PVC film spectra after testing with the Q and AB isolates are observed in dashed lines in Figure 4. The main difference among the spectra from the PVC blank film and the two films from AB and Q treatment, lies in a baseline drop off that is much more remarkable at the left of the spectra from AB and Q isolates. This is explained because of the physical changes in these films, like the observed cracks, which could make the surface rougher causing scattering of the infrared light, that is more visible at greater wavenumbers. Figure 4 also shows the occurrence of a new band near 1700 cm-1 which could be an evidence of polymeric oxidation and hydrolysis.
3.3 Molecular identification of the two fungal isolates with better results
Isolates Q and AB showed the best results in the screening test with PVC films, from the morphological characterization, shown in Table 1. We observe that these isolates belong to Mucor and Penicillium genera, respectively. Moreover, we confirmed these results by sequencing the ITS4 and ITS5 of the 18S ribosomal gene. The comparison of the obtained sequences with the Genbank databases, showed that the Q sequence has 99% similarity with sequences of the genus Mucor sp. The sequence obtained for AB showed 99% similarity with sequences from Penicillium expansum species. From the results of % similarity of the sequences compared with the Genbank database; the phylogenetic analysis shown in Figure 5 was carried out.
In figure 5, dendrogram constructed from the sequences obtained from ITS4 and ITS5 of the 18S ribosomal gene using Mega X (Kumar et al., 2018). Neighbor Joining (Kimura, 1980) was used as clustering algorithm and Kimura 2-parameter (Felsentein, 1985) as distance matrix. The number of nodes represents the Bootstrap percentage values based on 1000 replicates. Figure 5 also corroborates the morphological characterization presented in Table 1 for isolates Q and AB, and the macroscopic appearance of this fungi are shown in Figure 6.
3.4 Mucor sp., and Penicillium expansum growth curves
Figure 7 shows the growth curves results of the two selected morphospecies, Mucor sp., and Penicillium expansum. To evidence that fungus masses among weeks were statistically different, a one-way ANOVA analysis was performed, and difference between one week and another was checked by the t test for two equal variances. The growth curve for Mucor sp. (ANOVA: p<0.0001; F=79.72; df=15), shows that there are not big changes in mass gain in the first nine weeks, although t test showed significant differences in weeks 0 to 1, 1 to 2, 4 to 5 and 5 to 6 (p<0.05), these differences could be seen as attempts done for the fungi trying to find an enzymatic way to degrade the PVC films, as it was the only carbon source available in the test culture medium. From week nine, a sustained mass gain is observed until the last week in which the experiment was run (fifteen weeks in total), demonstrating that the process undergone from week 0 to 9 was adaptation to the conditions, and that the fungi finally found an enzymatic way to take advantage of available nutrients, going from the adaptation phase to the logarithmic growth phase.

Figure 7 Growth curves for Mucor sp. and Penicillium expansum. Standard deviation of triplicate measurements is shown as error bars.
Regarding mass gain, Ji-Dong Gu (2003) showed that polymers such as PVC have potential substrates for fungi, since these organisms have enzymes such as extracellular and intracellular depolymerases that participate in biological degradation. So, the increase in mass gain of a fungus is related to the action of exoenzymes that decompose polymers, since they produce short chains that can pass the semi-permeable wall and then being used as carbon and energy sources. This process is known as depolymerization (Gu, 2003).
The growth curve (Figure 7) for Penicillium expansum shows statistically significant differences among weeks (ANOVA: p<0.0001; F=9.78; df=15). However, t test showed significant differences just in weeks 0 to 1, 9 to 10 and 10 to 11 (p<0.05). Of these pairs of weeks, there is only an appreciable increase in mass in weeks 0 to 1, thus, this curve shows that the fungi remain in an adaptation phase, that does not achieve a logarithmic phase within the study time (fifteen weeks), in contrast to what was observed with Mucor sp. Although, fungus dry mass does not decrease either in the last weeks, which shows that eventually the fungi would find an enzymatic way to feed on the PVC film if the test were carried out for a longer period (Vrabl, Schinagl, Artmann, Heiss, & Burgstaller, 2019).
Infrared analysis makes possible to determine changes in the chemical composition of PVC films. In Figure 8, the infrared spectra of PVC films are shown, corresponding to week 15th of the study after the action of the species Mucor sp., and Penicillium expansum. The figure shows a reduction in the peaks between 3000 and 2900 cm-1 corresponding to the C-H bond. In addition, the raw spectra for these PVC films, showed a more marked baseline drop off compared with the spectra obtained for the screening test, which is consistent with a longer treatment time that caused more physical changes in the films and a rougher surface that increased the infrared light scattering phenomenon.

Figure 8 IR spectra obtained from PVC films from 15th week of growth curves for Mucor sp., and Penicillium expansum.
The infrared spectra changes shown in Figure 8 are consistent with the results mentioned on the work published by Kirbas, Guner and Keskin (1999), in which they found degrading action in the fungal species Pleurotus, Poliporus versicolor and Phanerochaete chrysosporium. They found changes in the C-H bond with a decrease of 82.15% measured by FTIR. In addition, Webb et al. (2000) carried out a study of colonization by fungi and biodeterioration of PVC, which included, among other fungal strains, Penicillium glabrum. They found that this fungus produces extracellular esterases that degrade plasticizers and cause the degradation of PVC. In this research, we found two fungi that showed the best results, one of them belonging to genus Penicillium, which could use a similar enzymatic way to take advantage of PVC. Likewise, fungi can degrade PVC by means of a dehydrochlorination process, this reaction was evidenced by Kaczmarek and Bajer (2007). They tested PVC containing cellulose degradation by Trichoderma koningi, Fusarium oxysporu and Penicillium sp., finding significant changes in C-Cl bonds peaks on IR spectra. The other fungus found in the present work belongs to the genus Mucor sp. About it, Grisa et al. (2011) carried out studies on the biological degradation of PVC in a sanitary landfill, one of the strains that showed the best results was an isolate of Mucor spp. Similarly, Grisa found important changes in the region of the C-H bond of the infrared spectrum as found in the analysis shown above. These works are the few found in the scientific literature that show that PVC degradation capacity has been found in fungi belonging to the genera Penicillium and Mucor, and that fungi from these genera can have an enzymatic battery that allows them to degrade a variety of this polymer bonds.
4. Conclusions
Mucor sp., was able to grow from a culture medium with PVC as the only carbon source, which evidences that this fungal strain could take advantage of it. In addition, we obtained the FTIR spectra of PVC films, that demonstrate that the polymer undergoes physical and chemical changes produced by this fungus. Furthermore, Penicillium expansum showed promising results in the screening test, but it could not reach the exponential growth phase in the growth curve. However, it did not reach a death phase in the time the experiment was performed, which showed that it could need a longer test time. Although, we found encouraging results, this work requires further study to optimize the growth conditions of the fungi to degrade PVC and to understand the mechanisms used for it, since the biodegradation of PVC seems to be possible. Although there are not many papers published in the literature on the matter, some of these, including this work, show the degrading activity of fungi on this material, which is a promising alternative to manage PVC waste.